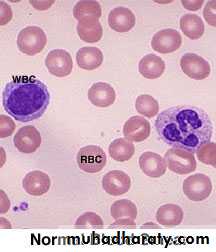
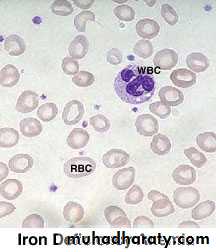
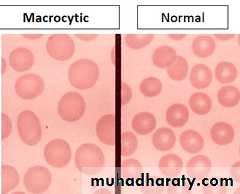

Approach to Anaemia and Bleeding Tendency
Dr. ALI A. YOUNISباطنية / د . علي (م 1)
ثالث طب
5 / 10 / 2016
1
Anaemia
Anaemia refers to a state in which the level of haemoglobin in the blood is below the reference range appropriate for age and sex.Other factors, including pregnancy and altitude, also affect haemoglobin levels and must be taken into account when considering whether an individual is anaemic.
The clinical features of anaemia reflect diminished oxygen supply to the tissues .
A rapid onset of anaemia (e.g. due to blood loss) causes more profound symptoms than a gradually developing anaemia.
Individuals with cardiorespiratory disease are more susceptible to symptoms of anaemia.
2
Causes of anaemia
3
Clinical assessment
Iron deficiency anaemia is the most common type of anaemia worldwide. A thorough gastrointestinal history is important, looking in particular for symptoms of blood loss.Menorrhagia is a common cause of anaemia in premenopausal females, so women should always be asked about their periods.
A dietary history should assess the intake of iron and folate, which may become deficient in comparison to needs (e.g. in pregnancy or during periods of rapid growth).
4
Clinical assessment
Past medical history may reveal a disease which is known to be associated with anaemia, such as rheumatoid arthritis (anaemia of chronic disease), or previous surgery (e.g. resection of the stomach or small bowel, which may lead to malabsorption of iron and/or vitamin B12).Family history and ethnic background may raise suspicion of haemolytic anaemias, such as the haemoglobinopathies and hereditary spherocytosis. Pernicious anaemia may also be familial.
5
Clinical assessment
A drug history may reveal the ingestion of drugs which cause blood loss (e.g. aspirin and antiinflammatory drugs), haemolysis (e.g. sulphonamides) or aplasia (e.g. chloramphenicol).6
7
8
Specific findings related to the aetiology of the anaemia
A patient may be found to have a right iliac fossa mass due to an underlying caecal carcinoma.Haemolytic anaemias can cause jaundice.
Vitamin B12 deficiency may be associated with neurological signs, including peripheral neuropathy, dementia and signs of subacute combined degeneration of the cord.
Sicklecell anaemia may result in leg ulcers, stroke or features of pulmonary hypertension.
9
Investigations
Schemes for the investigation of anaemias are often based on the size of the red cells, which is most accurately indicated by the MCV in the FBC. Commonly, in the presence of anaemia:• A normal MCV (normocytic anaemia) suggest either acute blood loss or the anaemia of chronic disease (ACD).
• A low MCV (microcytic anaemia) suggests iron deficiency or thalassaemia .
• A high MCV (macrocytic anaemia) suggests
vitamin B12or folate deficiency or myelodysplasia.
10
11
12
13
14
15
Bleeding
Normal bleeding is seen following surgery and trauma.Pathological bleeding occurs when structurally abnormal vessels rupture or when a vessel is breached in the presence of a defect in haemostasis. This may be due to a deficiency or dysfunction of platelets, to the coagulation factors, or occasionally to excessive fibrinolysis, which is most commonly observed following therapeutic thrombolysis .
16
Clinical assessment
Site of bleeding. Bleeding into muscle and joints, along with retroperitoneal and intracranial haemorrhage, indicates a likely defect in coagulation factors. Purpura, prolonged bleeding from superficial cuts, epistaxis, gastrointestinal haemorrhage or menorrhagia is more likely to be due to thrombocytopenia, a platelet function disorder or von Willebrand disease. Recurrent bleeds at a single site suggest a local structural abnormality.17
Clinical assessment
Duration of history. It may be possible to assess whether the disorder is congenital or acquired.Precipitating causes. Bleeding arising spontaneously indicates a more severe defect than bleeding that occurs only after trauma.
Surgery. Ask about operations. Dental extractions, tonsillectomy and circumcision are stressful tests of the haemostatic system. Immediate postsurgical bleeding suggests defective platelet plug formation and primary haemostasis; delayed haemorrhage is more suggestive of a coagulation defect. In postsurgical patients, persistent bleeding from a single site is more likely to indicate surgical bleeding than a bleeding disorder.
18
Clinical assessment
Family history. While a positive family history may be present in patients with inherited disorders, the absence of affected relatives does not exclude a hereditary bleeding diathesis; about onethird of cases of haemophilia arise in individuals without a family history, and deficiencies of factor VII, X and XIII are recessively inherited. Recessive disorders are more common in cultures where there is consanguineous marriage.Drugs. Use of antithrombotic, anticoagulant and fibrinolytic drugs must be elicited. Drug interactions with warfarin and druginduced thrombocytopenia should be considered. Some ‘herbal’ remedies may result in a bleeding diathesis.
19
Clinical assessment
Clinical examination may reveal different patterns of skin bleeding.
Petechial purpura is minor bleeding into the dermis that is flat and nonblanching
Petechiae are typically found in patients with thrombocytopenia or platelet dysfunction.
Palpable purpura occurs in vasculitis. Ecchymosis, or bruising, is more extensive bleeding into deeper layers of the skin.
The lesions are initially dark red or purple but become yellow as haemoglobin is degraded.
20
Clinical assessment
Retroperitoneal bleeding presents with a flank haematoma.Telangiectasia of lips and tongue points to hereditary haemorrhagic telangiectasia .
Joints should be examined for evidence of haemarthroses.
A full examination is important, as it may give clues to an underlying associated systemic illness such as a haematological or other malignancy, liver disease, renal failure, connective tissue disease and possible causes of splenomegaly.
21
22
23
Thrombocytopenia (low platelet count)
24
25
Thrombocytopenia (low platelet count)
Spontaneous bleeding does not usually occur until the platelet count falls below 20 ×109/L, unless their function is also compromised.Purpura and spontaneous bruising are characteristic but there may also be oral, nasal, gastrointestinal or genitourinary bleeding.
Severe thrombocytopenia (<10 ×109/L) may result in retinal haemorrhage and potentially fatal intracranial bleeding, but this is rare.
26
Thrombocytopenia (low platelet count)
Investigations are directed at the possible causes.
A blood film is the single most useful initial investigation.
Examination of the bone marrow may reveal increased megakaryocytes in consumptive causes of thrombocytopenia, or the underlying cause of bone marrow failure in leukaemia, hypoplastic anaemia or myelodysplasia.
27